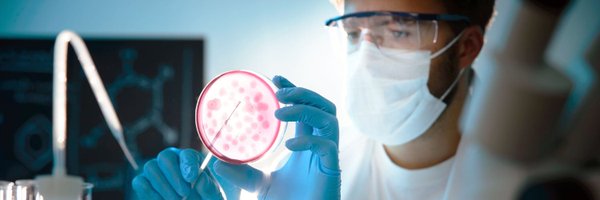

UKCPA Infection Committee
@UKCPAPIN
Followers
2K
Following
1K
Media
94
Statuses
2K
Official Twitter feed of the UKCPA Infection Committee.
UK
Joined April 2015
Published @RxMagazine: UK pharmacists have strong presence at international infectious disease @ESCMID conference #ESCMIDGlobal24
https://t.co/LTEEXdLM6o Thank you @mcgarrityorlagh @MGilchrist123 cc @UKCPA @UKCPAPIN @rpharms
#PharmacyResearch
0
10
20
UK #AMR National Action Plan for 2025-29 launched. @BSACandJAC @biainfection @UKCPAPIN @rpharms @ESGAP_ABS @NHSNEY
gov.uk
The government has announced its new national action plan on antimicrobial resistance to protect people and animals from the risk of drug-resistant infections.
0
20
37
#ESPAUR will feature at the British Infection Association @Biainfection 26th Annual Clinical and Scientific Meeting by on Tuesday 7 & Wednesday 8 May at Mercure Bristol Grand Hotel. Registration via https://t.co/C8EqPiADcI
#BIASpring2024
0
3
7
Another reason to celebrate today! We have been awarded a contract by @NHSEngland to deliver 200 fully funded CPD places for pharmacists and techs working in critical care: https://t.co/3hxnepvlyI. Education designed and delivered by @UKCPACritcare
hee.nhs.uk
1
22
51
INVITATION: We are now working on a paediatric IV to Oral Switch Tool and Criteria #IVOST Please contribute to our consensus gathering through a short (12-min) survey. Closes 21 Feb https://t.co/U7uS7ft1YF Pls cascade on & off social media 🙏🏾
Thank you to all who cascaded #IVOST survey and responded 🙏🏾. Co-production w/ >260 colleagues across the 4 UK nations over 4-stages. Gratitude tonight as @E_J_Harvey & I worked through final comments from stage 4 feedback ahead of workshop tomorrow to finalise the tool.
0
24
24
We are getting very close to 200,000 #AntibioticGuardian pledges 🙌🏾 🤞🏾 will capture it at 200,000
#WorldAMRAwarenessWeek 2023 ended w/ 195,691 #AntibioticGuardian pledges 9am 25.11.23; 195,763 = 20,000 pledges since end of #WAAW 2022 Individually & collectively taking action to tackle #AntimicrobialResistance. Thank you to all champions AG remains an always on campaign
1
11
38
Really important piece around ensuring antimicrobial stewardship principles are adhered to within virtual wards - thanks to all for coming together on this @DrDianeAshiru @DrKieranHand @raseaton66 @DafyddSiencyns @bsacceo @drLouDunsmure @jamiesonce @ceriphi & more! @UKCPAPIN
Our Antimicrobial Expert Advisory Group, in collaboration with @BSACandJAC, has released a statement to complement our interim standards for hospital at home and virtual ward pharmacy services, providing the antimicrobial context: https://t.co/82SaT2MH8K
0
13
27
Our Antimicrobial Expert Advisory Group, in collaboration with @BSACandJAC, has released a statement to complement our interim standards for hospital at home and virtual ward pharmacy services, providing the antimicrobial context: https://t.co/82SaT2MH8K
1
11
17
Fantastic collaboration around stability of aciclovir in elastomeric devices for OPAT.First antiviral of the programme! 🇦🇺 @b_fekade @jasonroberts_pk 🇬🇧 @jamiesonce @raseaton66 @BSACandJAC & those not on X
0
11
33
Join us at 11am today for the Infection Network Journal Club With Nav Nagi from Imperial College NHS Trust
1
2
5
@BeneHuttner talking about @WHO #AWaRe categories at @BSACandJAC #Infection2023 1/5 @UKCPAPIN @biainfection @DrDianeAshiru @DrKieranHand
1
2
6
#WorldAMRAwarenessWeek 2023 ends with 195,691 #AntibioticGuardian pledges & 989 organisations. The AG campaign remains an always on campaign beyond #WAAW/#EAAD. 19,928 pledges since end of #WAAW 2022 Individually & collectively taking action to tackle #AntimicrobialResistance
World Antimicrobial Awareness Week 2022 ends with 175,763 #AntibioticGuardian pledges. The AG campaign has remained an always on campaign beyond #WAAW #EAAD. We will continue to raise awareness and take actions to tackle #AntimicrobialResistance #WAAW2022
2
8
32
Throughout #WorldAMRAwarenessWeek, there were 3 cross-cutting themes underpinning the daily themes across 5 days; ** Children, ** Sustainability, ** Tackling inequalities Blog from UK-PAS by @aliciad3
https://t.co/tTUxcBUuGN
#ESPAUR
#AntibioticGuardian
#WAAW2023
#WAAW
1/Weekday 5 #WAAW #WAAW2023: #Antimicrobialresistance - #OneHealth and research **Environmental considerations, e.g disposal of antibiotics & environmental contamination. **One Health approaches to tackling AMR ** AMR research #AntibioticGuardian
#KeepAntibioticsWorking
0
3
11
It was wonderful to have our friends from Ghana join us today to learn more about how Scotland has been working to safeguard antibiotics, and to hear about our plans for the future. We're delighted to have this opportunity to share knowledge between our two countries #SAPG15
1
7
25
Today marks the last day of #WAAW – become an #AntibioticGuardian and let’s #KeepAntibioticsWorking together!
0
4
4
1/Weekday 5 #WAAW #WAAW2023: #Antimicrobialresistance - #OneHealth and research **Environmental considerations, e.g disposal of antibiotics & environmental contamination. **One Health approaches to tackling AMR ** AMR research #AntibioticGuardian
#KeepAntibioticsWorking
1/ Weekday 4 #WAAW #WAAW2023: Antimicrobials: untrue allergy labels & de-labelling spurious antibiotic allergy labels Future learn course https://t.co/qqWswCzFrZ Pharmacist checklist @rpharms
https://t.co/O36fFalsOn Vlogs on #AntibioticGuardian website https://t.co/iZKCtX6690
1
15
19
#WAAW daily theme 🌍 Scale & spread of our 🌱#IVOST #metronidazole #AMS initiative in @NHSGGC= ⬇️ IV use ⬇️ #plastic waste ⬇️ #Carbon 👣 ⬇️ costs & ⬆️ #nurse ⏰ saved 👇 https://t.co/BqkmtzYqV9
#AntibioticGuardian
@NHSGGCPharmacy @SusHealthcare @nes_qi @PharmDeclares
0
7
10
Are you really allergic to penicillin? If not, you could be missing out on the right medicine when you need it. Chair of our Antimicrobial Expert Advisory Group Mark Gilchrist explains more: https://t.co/VtMtzrV9NI
#Penicillin #WAAW #AMR @MGilchrist123
0
18
26